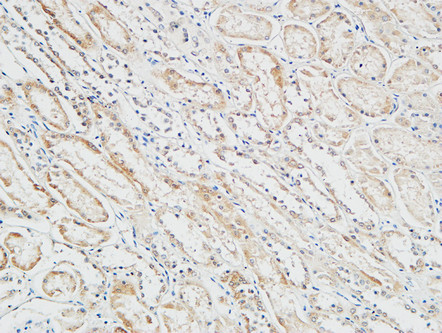

别名:PTCH1; PTCH; Protein patched homolog 1; PTC; PTC1应用:WB,IHC
反应种属:Human,Mouse
规格:50μl/100μl
| Description |
|---|
| This gene encodes a member of the patched gene family. The encoded protein is the receptor for sonic hedgehog, a secreted molecule implicated in the formation of embryonic structures and in tumorigenesis, as well as the desert hedgehog and indian hedgehog proteins. This gene functions as a tumor suppressor. Mutations of this gene have been associated with basal cell nevus syndrome, esophageal squamous cell carcinoma, trichoepitheliomas, transitional cell carcinomas of the bladder, as well as holoprosencephaly. Alternative splicing results in multiple transcript variants encoding different isoforms. Additional splice variants have been described, but their full length sequences and biological validity cannot be determined currently. |
| Specification | |
|---|---|
| Aliases | PTCH1; PTCH; Protein patched homolog 1; PTC; PTC1 |
| Entrez GeneID | 5727 |
| Swissprot | Q13635 |
| WB Predicted band size | Calculated MW: 161 kDa; Observed MW: 161 kDa |
| Host/Isotype | Rabbit IgG |
| Storage | Store at 4°C short term. Aliquot and store at -20°C long term. Avoid freeze/thaw cycles. |
| Species Reactivity | Human,Mouse |
| Immunogen | The antiserum was produced against synthesized peptide derived from human Patched. AA range:1-50 |
| Formulation | Liquid in PBS containing 50% glycerol, 0.5% BSA and 0.02% sodium azide, pH 7.3. |
| Application | |
|---|---|
| WB | 1/500-1/1000 |
| IHC | 1/50-1/100 |
| ELISA | 1/10000 |
![]() |
Immunohistochemical analysis of paraffin-embedded Human tonsils using PTCH1 antibody.High-pressure and temperature Tris-EDTA pH 8.0 was used for antigen retrieval. |
![]() |
Immunohistochemistry analysis of paraffin-embedded Human testis using PTCH1 antibody. High-pressure and temperature Tris-EDTA pH 8.0 was used for antigen retrieval. |
![]() |
Immunohistochemistry analysis of paraffin-embedded Human Right kidney using PTCH1 antibody.High-pressure and temperature Tris-EDTA pH 8.0 was used for antigen retrieval. |
![]() |
Immunohistochemistry analysis of paraffin-embedded Human Right kidney using PTCH1 antibody.High-pressure and temperature Tris-EDTA pH 8.0 was used for antigen retrieval. |
![]() |
Immunohistochemistry analysis of paraffin-embedded Human testis using PTCH1 antibody.High-pressure and temperature Tris-EDTA pH 8.0 was used for antigen retrieval. |
![]() |
Immunohistochemistry analysis of paraffin-embedded Human Right kidney using PTCH1 antibody. High-pressure and temperature Tris-EDTA pH 8.0 was used for antigen retrieval. |
本公司的所有产品仅用于科学研究或者工业应用等非医疗目的,不可用于人类或动物的临床诊断或治疗,非药用,非食用。
暂无评论
本公司的所有产品仅用于科学研究或者工业应用等非医疗目的,不可用于人类或动物的临床诊断或治疗,非药用,非食用。
中文

发表回复